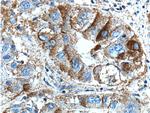
BEND3 Antibody in Immunohistochemistry (Paraffin) (IHC (P))

Search
Proteintech
BEND3 Polyclonal Antibody
{{$productOrderCtrl.translations['antibody.pdp.commerceCard.promotion.promotions']}}
{{$productOrderCtrl.translations['antibody.pdp.commerceCard.promotion.viewpromo']}}
{{$productOrderCtrl.translations['antibody.pdp.commerceCard.promotion.promocode']}}: {{promo.promoCode}} {{promo.promoTitle}} {{promo.promoDescription}}. {{$productOrderCtrl.translations['antibody.pdp.commerceCard.promotion.learnmore']}}
产品信息
23101-1-AP
种属反应
宿主/亚型
分类
类型
抗原
偶联物
形式
浓度
规格
纯化类型
保存液
内含物
保存条件
运输条件
产品详细信息
Product # 23101-1-AP specifically recognizes 85 and 94 kDa isoforms.
Immunogen sequence: PPRDDCYDS SSLPDDISVV KVEDSFEGER PGRRSKKIWL VPIDFDKLEI PQPDFEVPGA DCLLSKEQLR SIYESSLSIG NFASRLLVHL FPELFTHENL RKQYSCSGSL GKKQLDPSRI KLIRHYVQLL YPRAKNDRVW TLEFVGKLDE RCRRRDTEQR RSYQQQRKVH VPGPECRDLT SYAINPERFR EEFEGPPLPP ERSSKDFCKI PLDELVVPSP DFPVPSPYLL SDKEVREIVQ QSLSVGNFAA RLLVRLFPEL FTAENLRLQY NHSGACNKKQ LDPTRLRLIR HYVEAVYPVE KMEEVWHYEC IPSIDERCRR PNRKKCDILK KAKKVEK (493-828 aa encoded by BC131628 )
靶标信息
Transcriptional repressor which associates with the NoRC (nucleolar remodeling complex) complex and plays a key role in repressing rDNA transcription. The sumoylated form modulates the stability of the NoRC complex component BAZ2A/TIP5 by controlling its USP21-mediated deubiquitination (PubMed:21914818, PubMed:26100909). Binds to unmethylated major satellite DNA and is involved in the recruitment of the Polycomb repressive complex 2 (PRC2) to major satellites. Stimulates the ERCC6L translocase and ATPase activities (PubMed:28977671). [UniProt]
仅用于科研。不用于诊断过程。未经明确授权不得转售。
篇参考文献 (0)
生物信息学
蛋白别名: BANP, E5R, and Nac1 (BEN) domain 3; BEN domain-containing protein 3
基因别名: BEND3; KIAA1553
UniProt ID: (Human) Q5T5X7
Entrez Gene ID: (Human) 57673